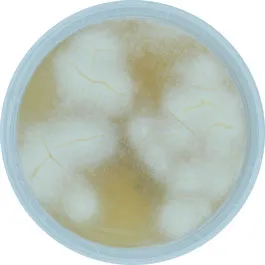

Sabouraud Chloramphenicol Agar
01-166
EP / ISO
Solid culture medium for the isolation of fungi according to ISO 16212 and 18416 standards.
Synonyms: SCA
EP / ISO
Solid culture medium for the isolation of fungi according to ISO 16212 and 18416 standards.
Synonyms: SCA

01-166
EP / ISO
Solid culture medium for the isolation of fungi according to ISO 16212 and 18416 standards.
Synonyms: SCA
Features
+See More
+See More
+See More

 Rest of the World
Rest of the World

















